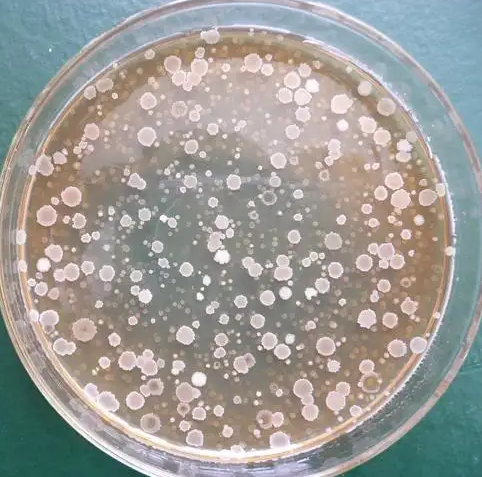

| 提交询价信息 |
| 发布紧急求购 |




价格:电议
所在地:北京
型号:
更新时间:2024-07-05
浏览次数:661
公司地址:北京市顺义区信中北街16号院3号楼4层432
![]()
李果(女士)
类干酪乳杆菌类干酪亚种
类干酪乳杆菌类干酪亚种是Lactobacillus属的微生物,原产地为中国。主要用途为研究;生产,具体用途为制作青贮饲料。发酵法生产高钙鸡骨泥,将鸡骨泥中的羟基磷酸钙转化为具有较高生理活性的L-乳酸钙。
菌种简介
平台编号:Bio-60566
提供形式:冻干物
拉丁属名:Lactobacillus Paracasei Ssp. Paracasei
中文名称:副干酪乳杆菌副干酪亚种
属名:Lactobacillus
种名加词:paracasei ssp. paracasei
来源历史:←北京林业大学食品科学系(1.0034)
收藏时间:2008.2.22
原始编号:5M1
资源归类编码:
模式菌株:非模式菌株
主要用途:研究;教学;生产
具体用途:发酵酸乳
特征特性:发酵葡萄糖、果糖、乳糖、蔗糖、麦芽糖、甘露糖、海藻糖;革兰氏阳性,菌体呈杆状,无芽孢,菌落圆形,接触酶阴性,兼性厌氧,15℃不生长 45℃生长。
生物危害程度:四类
致病对象:无
分离基物:酸乳
采集地:保定
培养基:酪蛋白胨 10.0g,牛肉膏 10.0g,酵母粉 5.0g,葡萄糖 5.0g,乙酸钠 5.0g,柠檬酸二铵 2.0g,Tween 80 1.0g,K2HPO4 2.0g,MgSO4.7H2O 0.2g,MnSO4.H2O 0.05g,CaCO3 20.0g,琼脂 15.0g,蒸馏水 1.0L,pH6.8。
培养温度:37℃
资源保藏类型:培养物
保存方法:真空冷冻干燥法
实物状态:有实物
共享方式:公益性共享;资源纯交易性共享;合作研究共享;资源交换性共享
源数据主键:22165
用途:研究;教学;生产;发酵酸乳
注意事项:仅用于科学研究或者工业应用等非医疗目的不可用于人类或动物的临床诊断或治疗,非药用,非食用(产品信息以出库为准)
欢迎访问微生物菌种查询网,本站隶属于北京百欧博伟生物技术有限公司,单位现提供微生物菌种及其细胞等相关产品查询、咨询、订购、售后服务!与国内外多家研制单位,生物医药,第三方检测机构,科研院所有着良好稳定的长期合作关系!欢迎广大客户来询!
 免责声明:以上所展示的[ 类干酪乳杆菌类干酪亚种]信息由会员[百欧博伟生物技术有限公司]自行提供,内容的真实性、准确性和合法性由发布会员负责。
免责声明:以上所展示的[ 类干酪乳杆菌类干酪亚种]信息由会员[百欧博伟生物技术有限公司]自行提供,内容的真实性、准确性和合法性由发布会员负责。